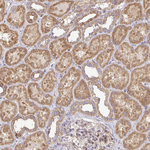
B4GALT6 Antibody in Immunohistochemistry (Paraffin) (IHC (P))

Search
Invitrogen
B4GALT6 Polyclonal Antibody
{{$productOrderCtrl.translations['antibody.pdp.commerceCard.promotion.promotions']}}
{{$productOrderCtrl.translations['antibody.pdp.commerceCard.promotion.viewpromo']}}
{{$productOrderCtrl.translations['antibody.pdp.commerceCard.promotion.promocode']}}: {{promo.promoCode}} {{promo.promoTitle}} {{promo.promoDescription}}. {{$productOrderCtrl.translations['antibody.pdp.commerceCard.promotion.learnmore']}}
产品信息
PA5-63547
种属反应
宿主/亚型
分类
类型
抗原
偶联物
形式
浓度
规格
纯化类型
保存液
内含物
保存条件
运输条件
RRID
产品详细信息
Immunogen sequence: TTYLPENFTY SPYLPCPEKL PYMRGFLNVN VSEVSFDEIH QLFSKDLDIE PGGHWRPKDC KPRWK
Highest antigen sequence identity to the following orthologs: Mouse - 86%, Rat - 88%.
靶标信息
This gene is one of seven beta-1,4-galactosyltransferase (beta4GalT) genes. They encode type II membrane-bound glycoproteins that appear to have exclusive specificity for the donor substrate UDP-galactose; all transfer galactose in a beta1,4 linkage to similar acceptor sugars: GlcNAc, Glc, and Xyl. Each beta4GalT has a distinct function in the biosynthesis of different glycoconjugates and saccharide structures. As type II membrane proteins, they have an N-terminal hydrophobic signal sequence that directs the protein to the Golgi apparatus and which then remains uncleaved to function as a transmembrane anchor. By sequence similarity, the beta4GalTs form four groups: beta4GalT1 and beta4GalT2, beta4GalT3 and beta4GalT4, beta4GalT5 and beta4GalT6, and beta4GalT7. The enzyme encoded by this gene is a lactosylceramide synthase important for glycolipid biosynthesis.
仅用于科研。不用于诊断过程。未经明确授权不得转售。
篇参考文献 (0)
生物信息学
蛋白别名: Beta-1,4-galactosyltransferase 6; Beta-1,4-GalTase 6; beta4GalT-VI; Glucosylceramide beta-1,4-galactosyltransferase; LacCer synthase; Lactosylceramide synthase; UDP-Gal:beta-GlcNAc beta-1,4-galactosyltransferase 6; UDP-Gal:betaGlcNAc beta 1,4- galactosyltransferase, polypeptide 6; UDP-Gal:glucosylceramide beta-1,4-galactosyltransferase; UDP-galactose:beta-N-acetylglucosamine beta-1,4-galactosyltransferase 6; unnamed protein product
基因别名: B4Gal-T6; B4GALT6; beta4Gal-T6
UniProt ID: (Human) Q9UBX8
Entrez Gene ID: (Human) 9331